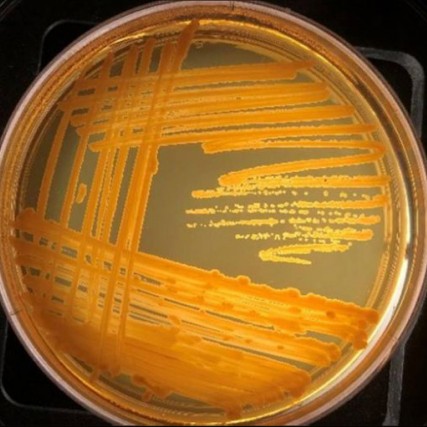
Petri dish showing orange zigzags of bacteria growth.

News
- RIT/
- Hudson Lab/
- News
-
December 17, 2019

Student to Student: Antibiotic resistant bacteria
After attending the College and Careers program at RIT, Kaylee Steiner discovered the Biotechnology program and realized it was more closely aligned with her interests.
-
September 23, 2019

RIT receives multiple accolades for promoting diversity and inclusion
RIT received the 2019 Higher Education Excellence in Diversity (HEED) Award from INSIGHT Into Diversity magazine, the oldest and largest diversity-focused publication in higher education, for the sixth year in a row. Also, for the third consecutive year, RIT is being honored as an institution committed to diversity for 2019 by Minority Access Inc. And Professor André Hudson, pictured above, is among the individuals Minority Access will celebrate at the National Role Models Conference this year.
-
August 23, 2019

Researchers gain new insight about bacteria within grapevine-killing crown gall tumors
Scientists have mapped the DNA of bacteria found within a chronic disease affecting grapevines, a feat they hope will ultimately help protect the multibillion-dollar grape industry that produces juice, jelly, wine and other important products.
-
August 6, 2019

RIT expands genomics research
RIT’s genomics research capabilities have evolved significantly over the past year. The university has invested heavily in revamping and equipping its Genomics Research Lab Cluster. The overhauled genomics facilities will boost capabilities for researchers in multiple disciplines, including bioinformatics, biotechnology and environmental science.
-
June 20, 2019

Podcast: Discovering New Bacterial Properties and Growing New Scientists
Intersections: The RIT Podcast, Ep. 17: Science professor André Hudson mentored three area high school students, and their collaboration led to the discovery that a rare bacterium kills E. coli and B. subtilis. The group published their findings in an academic journal. Hudson talks with Kit Mayberry, RIT vice president for strategic planning and special initiatives, about what he learned about himself as a teacher and a scientist on the project.
-
May 9, 2019
Rochester Prep students publish bacteria research in scientific journal
The Democrat and Chronicle reports on a scientific discovery made by three Rochester Prep High School students working with Andre Hudson, professor and department head of the Thomas H. Gosnell School of Life Sciences.
-
April 25, 2019

High school students publish paper with RIT scientists analyzing rare bacterium
Three high school students working in a science lab for the first time made a surprising discovery with an RIT professor. Now, the young women are co-authors on a scientific paper announcing a rare bacterium that kills e-coli.